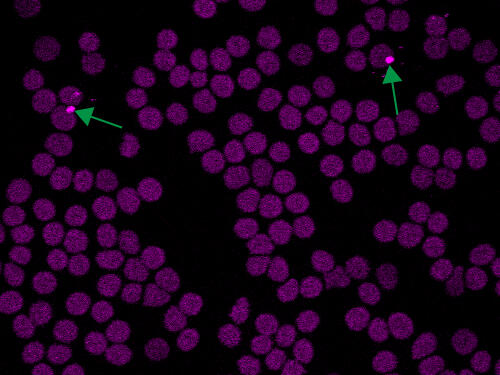
Malaria parasites inside red blood cells.

Hey,
I'm Alexei.
I'm a technical revenue leader with a PhD in biophysical chemistry who's cracked the code on bridging science and sales.Since 2019, I've: ✔ Driven $10M+ in scientific software revenue
✔ Helped 500+ researchers solve image analysis challenges
✔ Advanced from sales engineer to regional manager.Like you, I started with: ✘ Awkward discovery calls
✘ Ghosted by prospects
✘ Missed quotasThe secret to my turnaround?Bringing scientific rigor to revenue growth, accelerated by modern AI tools.Now, I'm on a mission to help technical sales professionals fast-track their way to success by doing the same.

Are you looking to:
Start your career in technical sales, applications, or customer success?
Crush your sales quota year after year by selling like a PhD scientist?
Rise into revenue leadership and lead your own team?
Ready to start your technical sales career?
I help fill the gap from STEM to your 1st commercial role
Once upon a time, you were a passionate STEM student.But something feels off: the default path isn't for you.You can't shake the feeling that your technical skills could make a bigger impact... and earn you a bigger paycheck.In 2025, companies are desperate for technical sales professionals who can navigate their customers' problems.Yet, many STEM graduates struggle to make this transition:
lacking basic business skills, overwhelmed by self-doubt and deathly afraid of "selling out."Amplify the same skills you learned in academia with a little persuasion and start a rewarding commercial career in technical sales, applications or customer success. ➤ Book a session to blueprint your technical sales career with a PhD scientist turned revenue leader.
I'll boost your journey with my insights from both sides of the interview table.
- Alexei


Ready to crush your sales quota?
I help technical sales professionals engineer their business success
Congratulations, you've made it into your dream role!But now the fresh business card smell fades and reality sets in:Your sales manager gave you a quota, and it seems crazy.The unfortunate truth is that many companies throw their new technical reps into the deep end without a life jacket.To hit.. and crush your quota, you'll need: ✔ A custom go-to-market plan grounded in buyer psychology. ✔ A clear, repeatable sales process leveraging persuasion. ✔ A proven framework to demo like a sales engineer.I'll show you how it all works with my science to revenue playbook. And boost it with my latest AI tactics. ➤ Book a strategy session to map your path to sales excellence and get proven insights from a sales leader.
I'll help you turn your late-night pipeline anxiety into early commission celebrations.
- Alexei
Ready to rise as a revenue leader?
I show reps how to become managers and managers how to lead
You've hit your targets to earn those top performer awards.But now you'd trade them all to lead your own team.The jump from rep to revenue leader is a quantum leap - one that requires a whole new skillset. To start, you'll need to: ✔ Scale your individual sales success to team performance ✔ Juggle tactical execution with long-term strategic planning ✔ Deliver sustainable growth and an accurate forecastMany sales stars stumble at this junction, struggling to let go of their individual contributor mindset and failing to lead. ➤ Book a consultation to chart your ascent to revenue leadership with a sales engineer turned regional manager.
I'll show you everything I wished I knew, and everything I learned along the way.
- Alexei


Ask me anything about technical sales in this free 30-minute consultation.
High Demand Note:
I'm committed to giving each client I work with my full attention, so I maintain a limited client roster.Due to overwhelming response, my discovery calls are currently fully booked.Join my waitlist below, and I'll notify you as soon as the next slots become available.

Contact me at alexei AT kazarine.com for any business inquiries.You can also connect with me on socials below:

Growing up in wintery Canada, I was curious about the world around me.Science felt like a natural fit. So after college, I entered a biophysical chemistry PhD.I built microfluidic devices and optical microscopes, met the love of my life, and published nine research papers along the way.
The research was exciting.
But the prospect of a lifetime in academia was terrifying.So, I started looking for other options while writing my thesis.Technical sales turned out to be exactly what I needed.A week after defending in 2019, I hopped on a flight to Boston to start my new life as a sales engineer for Imaris 3D/4D image analysis software.3 years in, I was promoted to lead the Imaris Americas team as Regional Manager - Imaris Sales & Customer Success.I worked with a fantastic team of 8 sales engineers and applications specialists to grow our Imaris business across the Americas, overseeing all revenue (new business, expansion, customer success)

In 2025, I took on the challenge of an expanded team as Regional Sales Manager, Imaging & Analysis - Central at Oxford Instruments.I now lead a team of 10 territory sales managers covering our materials analysis (EM, AFM, Raman, Nanoindentation, NMR) and Andor (scientific cameras, spectrometers, Imaris software) businesses for the US Central and Canada regions.When I'm not building our revenue org, I document my technical sales journey online to give other professionals a blueprint for navigating this exciting path.

I'm on a mission to bridge the gap between science and business by becoming a better revenue leader and leveraging the power of AI.As I explore this path, I'll share everything I discover with you.I'm currently obsessed with: ✔ Harnessing AI to transform sales processes.
✔ Building data-driven GTM strategies rooted in scientific principles.
✔ Leadership strategies for creating high-performing technical revenue teams.If these resonate with you, let's explore these frontiers together.You can find my latest ideas on LinkedIn.And if you want to accelerate your technical sales journey, feel free to book a 1:1 chat so I can map out the right shortcut for you.
My research story started with microfluidics
I've developed microfluidic devices for analytical and biomedical applications, including liquid-liquid extraction and microflow cytometry.I turned my 3D CAD designs into reality using rapid prototyping techniques ranging from precision CNC machining to PDMS-based soft lithography and xurography.

Designing the platform with 3D CAD

Microfluidic device assembled

Flow focusing for cytometry
Then I moved on to microscopes and big lasers
During my PhD, I switched to building advanced microscope systems for biomedical imaging.I've contributed to 3 custom fluorescence microscopes: widefield/TIRF, lightsheet, and nonlinear (2P/3P).I designed software for microscope control and worked on optomechanics, laser alignment and automation.

Lightsheet microscope

Nonlinear (2P/3P) microscope

Aligning ultrafast lasers (TiSaph + OPO)
I found new ways to study tissue with nonlinear imaging
For my PhD thesis, I used the nonlinear microscope I built to establish new solutions to overcome the limitations of classic histology.1) I leveraged the label-free nature of third-harmonic generation imaging and automated image analysis to detect and quantify malaria parasites in clinical samples.2) I took advantage of the intrinsic 3D optical sectioning of nonlinear imaging to create a virtual histology technique to study collagen and elastin microstructures for vocal fold regeneration.3) I identified novel nonlinear properties of common dyes that enable high-contrast imaging of histological features.
Malaria parasites inside red blood cells.

Rabbit vocal folds

Nonlinear histology
I believe in making research accessible, so I've provided PDF downloads and journal links for all my work.Whether you're exploring microfluidics, analytical techniques or biomedical imaging, you'll find everything below.If any of this research helps advance your own work, I'd appreciate your citation.
| Thesis | Title | Year | Download |
|---|---|---|---|
| PhD | Kazarine, A.,. Nonlinear Microscopy as a Tool for Histological Examinations (Doctoral dissertation, McGill University Libraries). | 2019 | |
| Masters | Kazarine, A.,. Image Segmentation Applied to Volumetric Measurements on Centrifugal Microfluidic Platforms in Motion (Masters dissertation, McGill University Libraries). | 2014 |
| Article | Year | Link | Download |
|---|---|---|---|
| Gopal, A. A., Kazarine, A.,,Dubach J.M, & Wiseman, P. W. Recent Advances in Nonlinear Microscopy: Deep Insights and Polarized Revelations. The International Journal of Biochemistry & Cell Biology, 105896. | 2020 | Link | |
| Kazarine, A., Gopal, A. A. & Wiseman, P. W. Nonlinear Microscopy of Common Histological Stains Reveals Third Harmonic Generation Harmonophores. Analyst, 144, 3239-3249 | 2019 | Link | |
| Kazarine, A., Kolosova, K., Gopal, A. A., Wang, H., Tahara, R., Rammal, A., … & Wiseman, P. W. Multimodal virtual histology of rabbit vocal folds by nonlinear microscopy and nano computed tomography. Biomedical Optics Express, 10(3), 1151-1164. | 2019 | Link | |
| Kazarine, A., Baakdah, F., Gopal, A. A., Oyibo, W., Georges, E., & Wiseman, P. W.. Malaria Detection by Third Harmonic Generation Image Scanning Cytometry. Analytical Chemistry, 91, 3, 2216-2223 | 2019 | Link | |
| Kazarine, A., Bouhabel, S., Douillette, A. H., Kost, K., Li-Jessen, N. Y., Mongeau, L., & Wiseman, P. W. Multimodal imaging of vocal fold scarring in a rabbit model by multiphoton microscopy. In Multiphoton Microscopy in the Biomedical Sciences XVII (Vol. 10069, p. 100692E). International Society for Optics and Photonics. | 2017 | Link | |
| Rouger, V., Alchini, R., Kazarine, A., Gopal, A. A., Girouard, M. P., Fournier, A. E., & Wiseman, P. W. Low-cost multimodal light sheet microscopy for optically cleared tissues and living specimens. Journal of biomedical optics, 21(12), 126008. | 2016 | Link | |
| Swayne, L., Kazarine, A., Templeton, E. J., & Salin, E. D. Rapid prototyping of pneumatically actuated hydrocarbon gel valves for centrifugal microfluidic devices. Talanta, 134, 443-447. | 2015 | Link | |
| Kazarine, A., & Salin, E. D. Volumetric measurements by image segmentation on centrifugal microfluidic platforms in motion. Lab on a Chip, 14(18), 3572-3581. | 2014 | Link | |
| Kazarine, A., Kong, M. C., Templeton, E. J., & Salin, E. D. Automated liquid–liquid extraction by pneumatic recirculation on a centrifugal microfluidic platform. Analytical chemistry, 84(16), 6939-6943. | 2012 | Link |